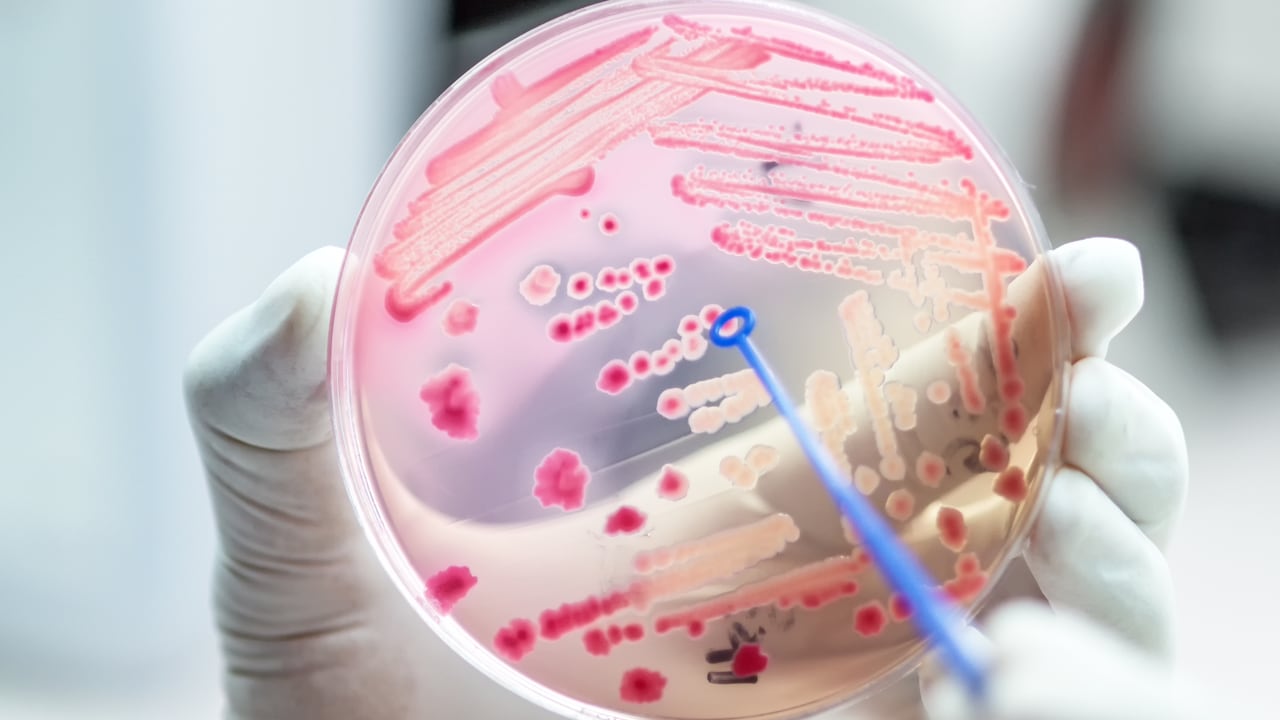
Los antibióticos eficaces son la base de la medicina moderna y son necesarios para procedimientos rutinarios como la cirugía o la terapia inmunosupresora.

Investigadores de la compañía farmacéutica Roche han desarrollado en las últimas semanas un nuevo antibiótico, la zosurabalpina, para tratar la bacteria multirresistente ‘Acinetobacter baumannii’, lo que no solo ofrece esperanzas a millones de pacientes, sino que también puede constituir un importante avance científico.
Se trata de una de las bacterias que encabezan las listas de patógenos prioritarios de la Organización Mundial de la Salud (OMS) y de amenazas urgentes de los Centros para el Control y la Prevención de Enfermedades (CDC) de Estados Unidos y que a menudo también están presentes en el entorno hospitalario. Allí pueden causar infecciones graves con una elevada tasa de mortalidad, sobre todo en pacientes vulnerables en cuidados intensivos.

En una investigación descrita en la revista Nature, los científicos de Roche y sus colaboradores Dan Kahne, catedrático Higgins de Química y Biología Química de la Facultad de Artes y Ciencias de Harvard (Estados Unidos), y Andrew Kruse, catedrático de Química Biológica y Farmacología Molecular de la Facultad de Medicina de Harvard, describen la nueva molécula, y cómo actúa para detener en seco la ‘Acinetobacter baumannii’.
El mecanismo de acción de esta clase de moléculas implica el bloqueo del transporte del lipopolisacárido bacteriano desde la membrana interna hasta su destino en la membrana externa, motivo de la resistencia a los antibióticos de siempre. Así, el fármaco trata eficazmente tanto ‘in vitro’ como en modelos de infección en ratones, superando los mecanismos de resistencia a los antibióticos existentes.

A diferencia de muchos antibióticos tradicionales, conocidos como antibióticos de amplio espectro, que pueden matar muchos tipos diferentes de bacterias --incluidas bacterias importantes y deseables que nos ayudan a las personas a mantenerse sanas en lugar de enfermas--, el nuevo antibiótico potencial es específico para dicha bacteria. En un modo de acción sin precedentes, impide que la bacteria construya adecuadamente su membrana protectora.
Y lo que es más importante: la nueva molécula ayudará a descubrir nuevos conocimientos biológicos sobre la construcción de las membranas bacterianas. Sin embargo, el objetivo final es desarrollar un posible nuevo medicamento que mate eficazmente lo que antes era una bacteria poco común y ahora es uno de los mayores retos de las enfermedades infecciosas para la salud pública.

“La resistencia a los antimicrobianos es lo que se denomina una ‘pandemia silenciosa’ y, en los próximos 30 años, se prevé que se cobre en todo el mundo más vidas que las que hoy se cobra el cáncer”, ha señalado el jefe de Enfermedades Infecciosas de Roche Pharma Research and Early Development (pRED), Michael Lobritz.
Los antibióticos eficaces son la base de la medicina moderna y son necesarios para procedimientos rutinarios como la cirugía o la terapia inmunosupresora. Sin embargo, con el tiempo, las bacterias evolucionan para evitar ser eliminadas por los antibióticos, desarrollando resistencia a uno o más fármacos y haciendo así ineficaces estos medicamentos.

A pesar de la necesidad de antibióticos y del aumento de la farmacorresistencia, desde 1968 no se ha comercializado ningún nuevo tipo de antibiótico eficaz contra una clase de patógenos conocidos como bacterias gramnegativas.
“El desarrollo de estos nuevos medicamentos potenciales es un viaje científico intenso, que empieza con la identificación de moléculas eficaces, sigue con el intento de comprender su estructura y su funcionamiento y, por último, realiza los ajustes de seguridad necesarios para reducir la toxicidad de la molécula para los pacientes”, concluyen desde Roche, en un comunicado.
Hasta ahora, los científicos de Roche han dedicado nueve años a desarrollar posibles nuevas moléculas antibióticas distintas de las desarrolladas hasta ahora.
* Europa Press